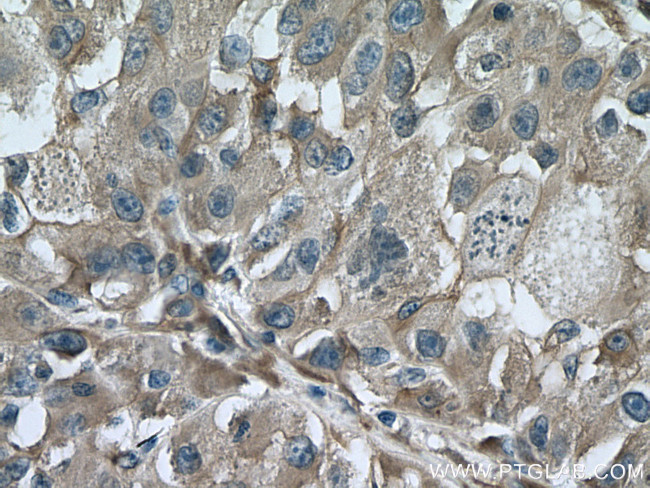
TTPA Antibody in Immunohistochemistry (Paraffin) (IHC (P))

Search
Proteintech
TTPA Monoclonal Antibody (3E7D10)
{{$productOrderCtrl.translations['antibody.pdp.commerceCard.promotion.promotions']}}
{{$productOrderCtrl.translations['antibody.pdp.commerceCard.promotion.viewpromo']}}
{{$productOrderCtrl.translations['antibody.pdp.commerceCard.promotion.promocode']}}: {{promo.promoCode}} {{promo.promoTitle}} {{promo.promoDescription}}. {{$productOrderCtrl.translations['antibody.pdp.commerceCard.promotion.learnmore']}}
产品信息
67431-1-IG
种属反应
宿主/亚型
分类
类型
克隆号
抗原
偶联物
形式
浓度
规格
纯化类型
保存液
内含物
保存条件
运输条件
产品详细信息
Aliquoting is unnecessary for -20°C storage.
靶标信息
This gene encodes a soluble protein that binds alpha-trocopherol, a form of vitamin E, with high selectivity and affinity. This protein plays an important role in regulating vitamin E levels in the body by transporting vitamin E between membrane vesicles and facilitating the secretion of vitamin E from hepatocytes to circulating lipoproteins. Mutations in this gene cause hereditary vitamin E deficiency (ataxia with vitamin E deficiency, AVED) and retinitis pigmentosa.
仅用于科研。不用于诊断过程。未经明确授权不得转售。
篇参考文献 (0)
生物信息学
蛋白别名: alpha TTP; Alpha-tocopherol transfer protein; Alpha-TTP; tocopherol (alpha) transfer protein (ataxia (Friedreich-like) with vitamin E deficiency); Tocopherol transfer protein alpha
基因别名: alpha-TTP; alphaTTP; ATTP; AVED; TPP1; TTP; TTP1; TTPA
UniProt ID: (Human) P49638, (Rat) P41034, (Mouse) Q8BWP5
Entrez Gene ID: (Human) 7274, (Pig) 100152248, (Rat) 25571, (Mouse) 50500